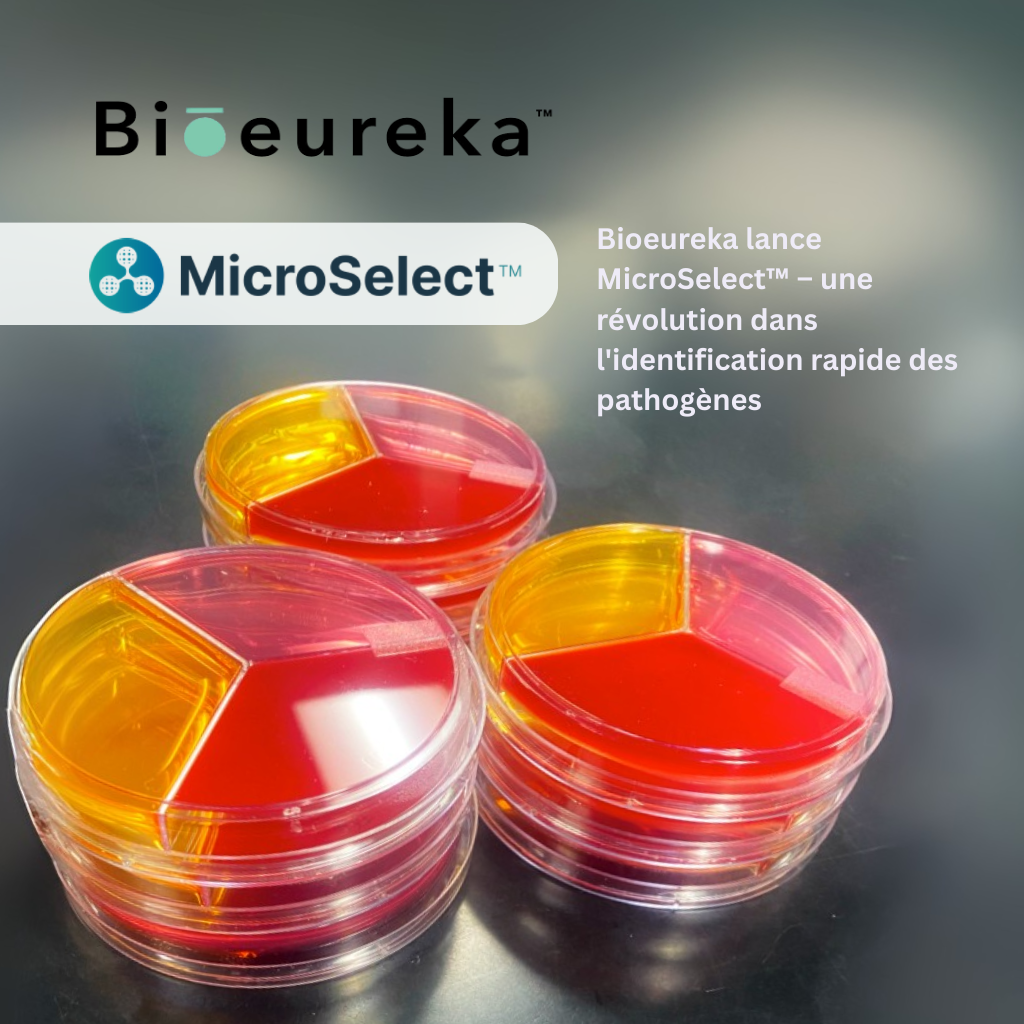

Actualités &publications
Découvrez nos actualités, publications et les dernières nouvelles de nos partenaires et membres. Restez à l’affût des avancées et enjeux qui façonnent les sciences de la vie au Québec!

L’ÉTS inaugure itechsanté, son nouvel institut de recherche et d’innovation en technologies pour la santé
L’École de technologie supérieure (ÉTS) a procédé hier à l’inauguration officielle d’itechsanté, son nouvel institut de…